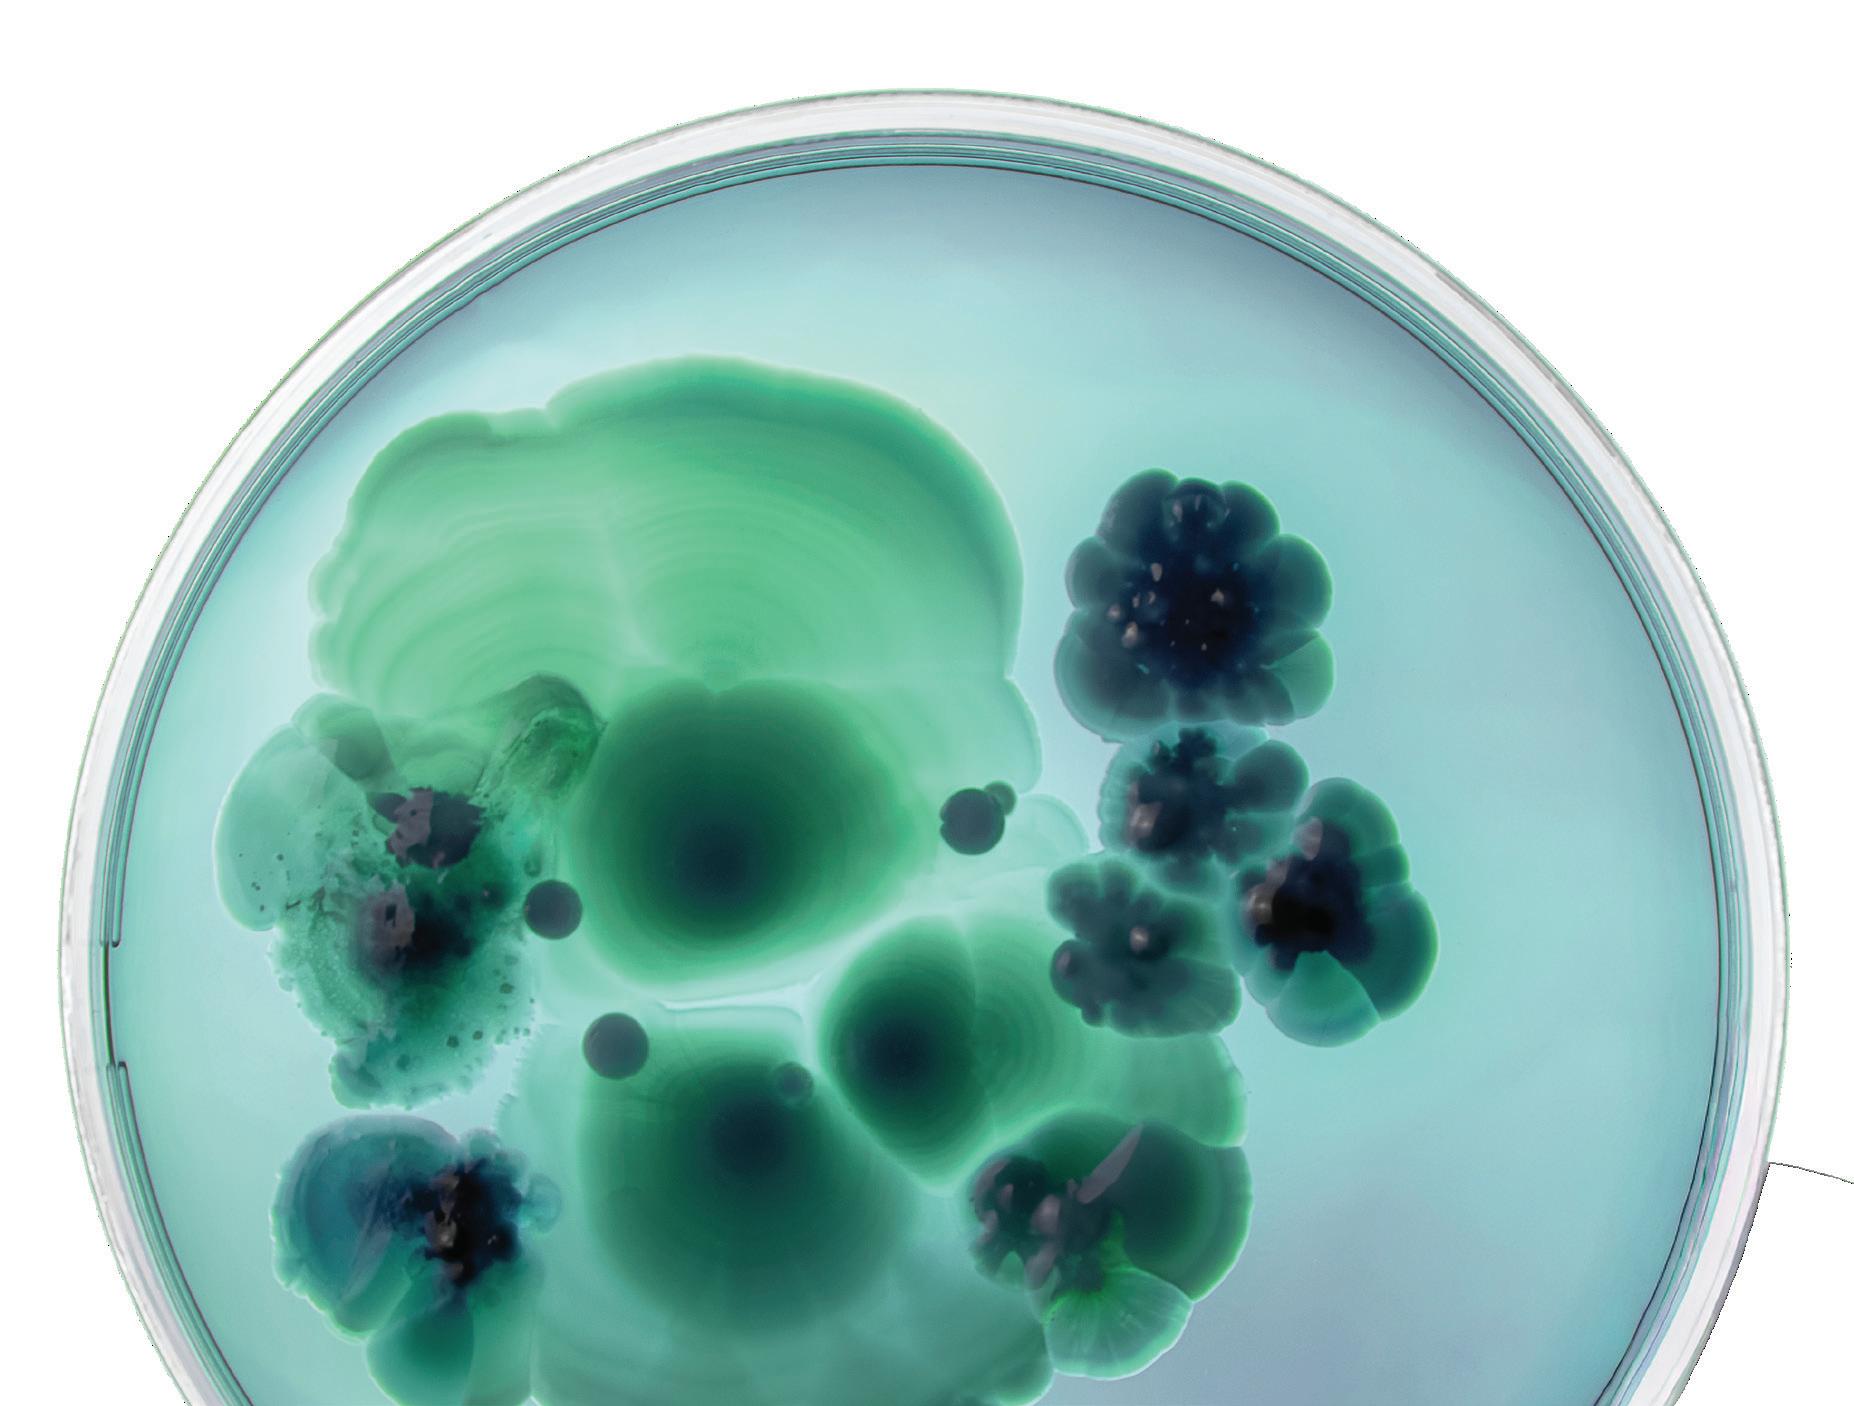

40%
6 120+ 40% 50% 1
Intellectual Property Litigation: Life Sciences
Half of our IP team have experience as scientists, engineers, and attorneys in top pharma, biotech, and tech companies.
With a legacy spanning decades, Honigman’s Life Sciences IP Litigation practice stands at the forefront of high-stakes patent and intellectual property disputes for innovators in pharmaceuticals, biologics, and medical devices. Our deep bench of award-winning litigators, many of whom hold advanced degrees in biological sciences and chemistry, leverages both legal and scientific knowledge to guide clients through the most complex disputes in U.S. District Courts, the USPTO’s Patent Trial and Appeal Board (PTAB), and the Federal Circuit. We have a proven record of securing results in competitor and bet-the-product litigations where hundreds of millions of dollars and critical market positions are at stake.
Key strengths of our approach
Strategic insight: Our team’s technical fluency covers the full spectrum of life sciences IP litigation, including Hatch-Waxman and biosimilar disputes as well as cases involving small molecules, biologics, antibodies, enzymes, genetically engineered organisms, and cutting-edge medical devices.
High-impact representation: We frequently serve as lead counsel in bench and jury trials, successfully advancing clients’ interests in complex matters that define their business trajectories.
Deep industry experience: As part of a 120+ strong multidisciplinary IP practice, we draw on the expertise of numerous PhDs and seasoned professionals with experience at major pharmaceutical companies and dynamic startups, ensuring that every legal strategy is firmly grounded in real-world scientific and business considerations.
Seamless integration across legal disciplines: Our life sciences litigators collaborate closely with their firm colleagues in patent prosecution, FDA regulatory counseling, corporate transactions, and antitrust litigation. This integrated approach allows us to anticipate challenges and deliver creative, business-focused solutions in every engagement.

Represented Merck and 3M in IPR actions and litigation against AptarGroup as it was seeking to enforce device patents allegedly covering Dulera® and Asmonex® products. Obtained a finding of invalidity of opponent’s IP after trial in IPR actions.

Won a $14.5 million patent verdict on behalf of DSM Bio-Based Products & Services in a seven-day jury trial involving genetically engineered yeast used for industrial-scale production of ethanol from corn stock.*

Successfully challenged a patent on an animal-protein-free botulinum toxin formulation for Galderma (PGR2019-00062). The patent owner conceded invalidity and canceled claims; the PTAB denied their motion to amend. The Federal Circuit affirmed the decision, securing a strong result.

Lead counsel for Ironwood Pharmaceuticals in Hatch-Waxman patent infringement litigation to protect clients’ prescription digestive drug, Linzess®. Obtained consent judgments with injunctions against all defendants.

We obtained a consent order and total victory for our client, KUB Technologies, Inc. — a leading manufacturer of x-ray and optical camera technology for cancer treatment — in an ITC investigation against an overseas cabinet x-ray maker infringing on their patent.

Defeated a petition for inter partes review of a patent covering pigmented ultra-high molecular weight polyethylene yarn used in medical-grade sutures and anchors utilized in orthopedic and cardiac surgeries for DSM Biomedical.*
*matter handled prior to joining Honigman LLP
What sets us apart
Trusted national leadership: recognized by industry rankings and clients for our expertise, Honigman serves as an extension of our clients’ in-house teams for established life sciences companies and trailblazing innovators alike.
Business-driven solutions: We go beyond litigation by offering pre-litigation assessments, strategic opinions, IP-related board presentations, and tailored counseling to help clients capture value, minimize risk, and accelerate market opportunities.
Commitment to results: At every turn, our focus is on safeguarding client innovation and paving the way for scientific and commercial success.
Honigman is an Am Law 200 full-service general business law firm with more than 350 attorneys. We serve clients locally, across the country, and around the world, counseling on complex issues in more than 60 areas of law. We understand our clients’ businesses and are exceptionally responsive to their business goals and needs. The proficiency and experience of our attorneys—backed by our client centric model and competitive cost structure—allow us to successfully compete with larger national firms.
